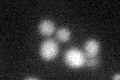
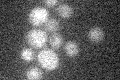

View description
18kDa catalytic subunit of the Signal Peptidase Complex (SPC; Spc1p, Spc2p, Spc3p, and Sec11p) which cleaves the signal sequence of proteins targeted to the endoplasmic reticulum
Localization:
Intensity:
Fold change:
Significance:
-
C’ GFP library in SD

below threshold15.38 -
N' NOP1pr-GFP in SD

ER69.0929 -
N' TEF2pr-mCherry in SD

cell periphery,vacuole24.955 -
N' NATIVEpr-GFP in SD

below threshold17.7072 -
N' TEF2pr-VC and Cyto-VN in SD

#N/A0 -
C’ GFP library in SD+DTT
cytosol15.671.01No -
C’ GFP library in SD+H2O2

cytosol14.320.93No -
C’ GFP library in Starvation Media
cytosol14.620.95No -
C’ GFP library on the background of Pup2-DaMP

below threshold -
C’ GFP library on the background of CCT mutant

below threshold14.51330.943433No
